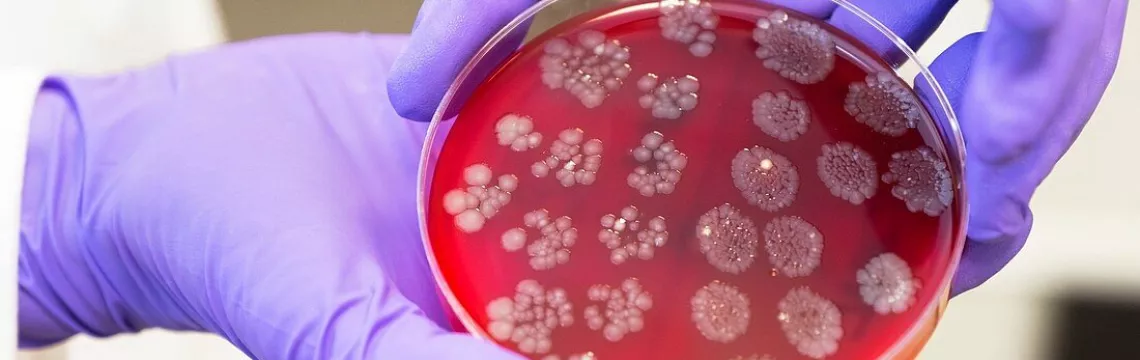
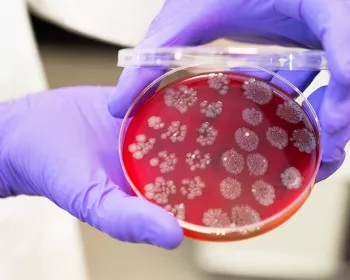

Microorganismos: microbios valiosos para la salud humana
Los microorganismos, criaturitas invisibles pero muy vivas y ultrasofisticadas, son imprescindibles para la vida en la tierra y para nuestra salud. ¿Qué servicios nos prestan? ¿Cómo protegerlos? ¿Por qué algunos de ellos provocan enfermedades? ¡Se lo contamos todo!
- Descubrir las microbiotas
- Microbiota y trastornos asociados
- Actuar en nuestras microbiotas
- Publicaciones
- Acerca del Instituto
Área para profesionales sanitarios
Encuentra aquí tu espacio dedicado
en_sources_title
en_sources_text_start en_sources_text_end
Acerca de este artículo

Microorganismos: criaturas microscópicas con macropoderes
Los microorganismos son seres vivos indetectables a simple vista, a veces llamados «microbios» o «gérmenes». Generalmente, constan de una sola célula y están por todas partes: desde los abismos hasta el fondo de nuestro intestino, pasando por el aire, el suelo, las plantas y los ríos.
Microorganismos: incansables trabajadores ocultos
Los microorganismos son esenciales para la vida en la tierra gracias a sus superpoderes. Por ejemplo, cabe mencionar su papel clave en la descomposición de los residuos vegetales y animales o su función esencial en la fijación del carbono y el nitrógeno. Por lo tanto, son los eslabones clave del funcionamiento de los ecosistemas terrestres, los aliados imprescindibles de la salud de los seres vivos.
Nuestro cuerpo constituye también un auténtico ecosistema en el cual viven en armonía con nosotros miles de millones de microorganismos «amigos» que nos prestan múltiples servicios; se habla de flora o de (sidenote: Microbiota La microbiota es la comunidad de microorganismos —bacterias en su mayoría, pero también virus, hongos y arqueas— que colonizan el organismo humano. Los tipos, el número y la distribución de estos microorganismos son muy diferentes según las zonas del cuerpo. La microbiota del intestino —también llamada «microbiota intestinal» o «flora intestinal»— es la que contiene la mayor cantidad de microorganismos. También es la más estudiada. En el ser humano, se encuentran microbiotas en la vagina (microbiota vaginal), en la superficie de la piel (microbiota cutánea), en las vías urinarias (microbiota urinaria), en las vías respiratorias (microbiota pulmonar) y en la zona de la boca, la garganta y la nariz (microbiota ORL). Estas numerosas microbiotas interactúan entre sí y desempeñan papeles importantes en las funciones digestivas, metabólicas, inmunitarias y neurológicas. ) . Este tipo de comunidades microbianas no solo se observa en los animales y las plantas, sino también en el suelo e incluso en los océanos 1.
500 millones Es el número de rinovirus, el virus responsable del resfriado, que podrían caber en una esfera del tamaño de una cabeza de alfiler.
1 mil millones Es el número de bacterias y el número de virus que contiene 1 g de heces.
1 mil millones También es el número de bacterias y el número de hongos que contiene 1 g de suelo.
La microbiota es la comunidad de microorganismos —bacterias en su mayoría, pero también virus, hongos y arqueas— que colonizan el organismo humano.
La microbiota del intestino - también llamada «microbiota intestinal» o «flora intestinal»
En el ser humano, se encuentran microbiotas :
Por cada bacteria, un servicio prestado al ser humano
- Las bacterias Rhizobium, al fijar el nitrógeno de la atmósfera al suelo en las raíces de las leguminosas, favorecen su crecimiento, a la vez que reducen el uso de abonos químicos.
- Las bacterias Lactobacillus acidophilus y Streptococcus thermophilus transforman la leche en yogur.
- El hongo Penicillium roqueforti transforma la leche cuajada y fermentada en queso azul o en roquefort.
- Unos virus llamados «fagos» nos permiten curar ciertas infecciones causadas por bacterias resistentes a los antibióticos.
- La levadura Saccharomyces cerevisiae transforma los azucares del trigo o la cebada en alcohol para la fabricación de la cerveza.
- Por último, un conjunto de bacterias, hongos y arqueas se encarga de purificar el agua en las estaciones de depuración de aguas residuales.
100 mil millones Es el número de bacterias que hay en 1 g de placa dental.
Historia de los microorganismos
- Hace 3,4 a 3,7 millones de años: aparición de las primeras bacterias y arqueas (primera forma de vida en la tierra).
- 1665: el científico inglés Robert Hook observa por primera vez microorganismos con un microscopio (mohos).
- 1674: el pañero holandés Antoni van Leeuwenhoek observa por primera vez bacterias con un microscopio; las llama «animalículos».
- 1838: el naturalista y zoólogo alemán Christian Gottfried Ehrenberg inventa la palabra «bacteria».
- 1857: Louis Pasteur pone en evidencia el papel de las bacterias en la fermentación.
- 1882: Robert Koch descubre el bacilo responsable de la tuberculosis.
- 1918: epidemia de gripe española causada por el virus H1N1 (25 millones de muertos).
- 1930: primera observación de virus con un microscopio electrónico.
- 1917: Félix d’Hérelle y Frédérick Tword descubren los bacteriófagos.
- 1929: Alexander Fleming descubre la penicilina (antibiótico).
- 1977: Carl Woes descubre las arqueobacterias.
- 1995: el equipo de Craig Venter realiza la primera secuenciación integral del genoma bacteriano.
- 2019: pandemia de COVID-19 (virus SARS-CoV-2).
Some definitions of microorganisms

Bacterias

Virus (incluidos fagos)

Protozoos

Microalgas

Hongos

Arqueas
Estos microorganismos son, junto con los virus, los más conocidos por el público general. En el aspecto microscópico, tienen formas muy variadas (bastoncillos, esferas, espirales…) y se encuentran por todas partes: plantas, animales, seres humanos, suelo, mares, etc. Las bacterias desempeñan un papel esencial en la descomposición de la materia orgánica animal y vegetal. Por suerte para nosotros, solo un pequeño número de ellas son parásitos o patógenos. Algunas deterioran los alimentos, mientras que otras mejoran su sabor y su conservación (fermentación). La mayoría de las bacterias que viven en simbiosis con el ser humano se encuentran en el aparato digestivo (microbiota). En el suelo, Nitrobacter transforma los nitritos en nitratos y Methanobacterium, los carbonatos en metano. Las bacterias propiónicas, por su parte, transforman la lactosa de la leche y le dan un aroma de avellana al emmental o el gruyer, mientras que ciertos estafilococos no patógenos contribuyen al afinado de los quesos y a la formación de la corteza 4.
Por desgracia, algunas bacterias son más conocidas por sus efectos negativos para la salud. En nuestra microbiota intestinal, la mayoría de Escherichia coli son inofensivas, pero algunas cepas pueden provocar intoxicaciones alimentarias. La bacteria Shigella, por ejemplo, es responsable de una enfermedad llamada shigelosis y de 212 438 fallecimientos en el mundo en 2016. Vibrio cholerae, por su parte, es responsable de las temidas epidemias de cólera y de 107 290 muertes registradas en 2016, generalmente en poblaciones pobres que no tienen acceso al agua potable 5. Otro ejemplo tristemente famoso es Clostridium tetani, que produce una toxina responsable del tétanos, o también Clostridioides difficile, una bacteria resistente a los antibióticos, principal responsable de las diarreas infecciosas nosocomiales, que pueden ser mortales en el adulto 5.
En la gran familia de los microorganismos, los virus se conocen como los más pequeños. Su estructura es muy sencilla: una molécula de ADN o de ARN rodeada de proteínas que forman una «cápside». Una de las particularidades de los virus es que dependen por completo de una célula huésped. En otras palabras, tienen que penetrar en la célula para utilizar su maquinaria a fin de replicarse, antes de infectar a nuevas células vecinas. Es lo que ocurre con los virus que infectan al ser humano (virus del SIDA, del resfriado, de la gripe…). Una vez liberados, esta célula huésped muere y los nuevos virus pueden atacar a otras células.
Aunque llevan una etiqueta a menudo muy negativa, sin embargo no todos los virus son patógenos para el ser humano, y algunos incluso son nuestros aliados. Es el caso de los virus llamados bacteriófagos o fagos (literalmente «comedores de bacterias»), que solo infectan bacterias. Los bacteriófagos, muy útiles para regular ciertas poblaciones bacterianas, ofrecen nuevas perspectivas terapéuticas y una alternativa a los antibióticos 4. Entre ellos, se encuentra Siphoviridae, Myoviridae y Podoviridae, que difieren de los virus «clásicos» por la presencia de una cola que les permite fijarse a las bacterias. Los bacteriófagos representan la mitad de las especies de virus conocidos en la actualidad 4.
En la microbiota, el conjunto de las comunidades virales forma lo que se llama el «viroma».
Los protozoos, menos conocidos por el público general, son microorganismos unicelulares que tienen formas muy variadas: cambiante, como la ameba, o fija y compleja, como el paramecio. Se encuentran principalmente en entornos variados y húmedos, sobre todo en el agua dulce, los medios marinos y el suelo. Pueden desplazarse con movimientos «amiboides» gracias a los cilios o propulsarse mediante flagelos. Algunos protozoos pueden infectar a las plantas y los animales, en especial al ser humano. Es el caso de Plasmodium falciparum, tristemente famoso en el mundo por causar formas graves de paludismo (o malaria) y temible durante los viajes a ciertos países 4.
Se encuentran en el agua dulce o el agua de mar, sobre todo en los océanos, los lagos y los ríos. Pueden desarrollarse a veces en los suelos y sobre las rocas húmedas, y en el pelaje de ciertos animales. Contienen clorofila, que les permite sintetizar su propio alimento a partir de la radiación solar. Las diatomeas son microalgas que, al final de su vida, se depositan en el fondo marino. La parte blanda se descompone y la pared mineral de sílice sedimenta bajo el efecto de la presión del agua 4.
El fitoplancton agrupa el conjunto de las microalgas presentes en el agua de mar. Forma parte, junto con las bacterias y los virus que también viven allí, de la «microbiota marina». Esta población diversificada de microorganismos representa más de dos terceras partes de la biomasa marina. Tiene una influencia positiva sobre el ecosistema oceánico y contribuye a la salud del planeta 1.
La mayoría de los hongos viven en el suelo y sobre los vegetales. Se distinguen 3 grandes grupos de hongos: los mohos filamentosos pluricelulares, los hongos filamentosos macroscópicos y las levaduras microscópicas unicelulares 4. En la naturaleza, los mohos y los hongos filamentosos participan en el ciclo del carbono a través de la formación de largos filamentos ramificados (micelios) capaces de descomponer la materia vegetal. El micelio más grande conocido, situado en el estado de Oregón (Estados Unidos), cubre una superficie de 9,7 km2. En el ámbito de la salud, Penicillium notatum es el origen del descubrimiento accidental de la penicilina por Alexander Fleming en 1928, uno de los avances científicos más importantes jamás conseguidos 6. En el ámbito agroalimentario, la utilización de ciertos hongos filamentosos es el origen de la fabricación de quesos. Penicillium roqueforti se emplea para afinar los quesos azules, y el complejo de especies Penicillium camemberti se usa para la fabricación de quesos de pasta blanda, como el camembert y el brie 6. Las levaduras, como Saccharomyces, son células que brotan a partir de una célula madre. La especie Saccharomyces cerevisiae se utiliza para la producción de vino y cerveza 6.
Algunos hongos son parásitos de plantas y les causan enfermedades, como el mildiu o la sarna. Solo un pequeño número de hongos afectan a la salud humana (tiña, algodoncillo…) o también la levadura Candida albicans en el caso de la candidiasis 4.
Las arqueas, muy similares a las bacterias, con las que se confundieron durante largo tiempo, son microorganismos unicelulares que a veces forman filamentos o amasijos. En la década de 1970, las investigaciones demostraron que eran distintas, desde el punto de vista evolutivo, de las bacterias. Comparten puntos comunes con las células eucariotas (como las nuestras), que tienen una estructura más compleja que la bacterias procariotas. Las arqueas son capaces de vivir en entornos extremos (fuentes de agua caliente, géiseres, hielo de la Antártida, etc.), a presiones y a concentraciones de sal elevadas y a temperaturas muy bajas o, al contrario, muy elevadas 4. Halobacterium o Halococcus viven en los lagos y, gracias a sus pigmentos, les dan un color rojo o amarillo, mientras que Pyrobaculum se reproduce bajo tierra, en los reservorios de petróleo, a más de 100 °C.

Ame a sus microbios, amor con amor se paga
¡Si pensaba que los microbios solo eran buenos para ser eliminados, habrá comprendido que estaba totalmente equivocado! La gran mayoría de ellos son imprescindibles para la vida y las actividades humanas. Debe saber que también son esenciales para el funcionamiento de nuestro organismo y para mantener una buena salud.
Intercambio de buenos modales 3, 7, 8
En efecto, somos el huésped de una multitud de microorganismos variados que se califican como «comensales» —para diferenciarlos de los microorganismos patógenos— y con los que constituimos una auténtica simbiosis. Porque, a cambio de alojamiento y comida, los microbios nos prestan inestimables servicios.
Unas cuantas cifras sorprendentes
5 quintillones (es decir 5 x 1030)
Es el número de bacterias y arqueas que viven en el planeta.
Es, con mucho, la forma de vida más extendida en la tierra.
100 millones de años-luz
Es la distancia que cubriría la alineación de los 1031 virus que viven en la tierra.
Hay 50 a 150 veces más genes diferentes en la microbiota que en las células del organismo humano. Por lo tanto, la microbiota representa un auténtico «segundo genoma» 3.
Hay 10 veces más bacterias que células en el ser humano.2
En el intestino, las bacterias de la microbiota se alimentan de las fibras alimentarias —que somos incapaces de degradar— y liberan a cambio valiosos compuestos llamados « (sidenote: Ácidos Grasos de Cadena Corta (AGCC) Los Ácidos Grasos de Cadena Corta (AGCC) son una fuente de energía (carburante) de las células de la persona que interactúan con el sistema inmunitario y están implicadas en la comunicación entre el intestino y el cerebro. Silva YP, Bernardi A, Frozza RL. The Role of Short-Chain Fatty Acids From Gut Microbiota in Gut-Brain Communication. Front Endocrinol (Lausanne). 2020;11:25. ) ». Estas moléculas alimentan a las células intestinales, participan en su crecimiento y su diferenciación, y refuerzan su función de barrera. Los microbios también sintetizan sustancias bioactivas útiles, como aminoácidos o vitaminas (K2, B5, B6…).
Además, participan en la maduración de las células inmunitarias, especialmente abundantes en la pared del intestino y, ocupando el terreno y sintetizando ciertas proteínas antibacterianas llamadas bacteriocinas, nos protegen contra la proliferación de microorganismos patógenos. Por último, sintetizan (sidenote: Metabolitos Moléculas pequeñas producidas durante el metabolismo celular o bacteriano. Por ejemplo, los ácidos grasos de cadena corta son metabolitos producidos por la microbiota intestinal durante la fermentación de azúcares complejos no digeribles (fibras…). Silva YP, Bernardi A, Frozza RL. The Role of Short-Chain Fatty Acids From Gut Microbiota in Gut-Brain Communication. Front Endocrinol (Lausanne). 2020;11:25. Lamichhane S, Sen P, Dickens AM, et al An overview of metabolomics data analysis: current tools and future perspectives. Comprehensive analytical chemistry. 2018 ; 82: 387-413 ) capaces de regular algunas de nuestras funciones fisiológicas, en especial la inmunitaria y la neuronal. Por ejemplo, existe una comunicación permanente entre la microbiota y el cerebro que se llama eje microbiota-intestino-cerebro.
Todo lo que necesita saber sobre el eje microbiota-intestino-cerebro
Cómo mimar a los microbios 3, 7, 8
La buena salud de la microbiota depende de múltiples factores: genética, edad, lugar de vida, forma del parto… Pero el modulador más potente de la microbiota intestinal es la alimentación. Para que sea favorable a una microbiota «sana», es decir, rica y diversificada, debe incluir suficientes vegetales variados (fruta, verdura, oleaginosas, cereales integrales, leguminosas…), que proporcionarán buenos «sustratos» a los microorganismos —la comida que les gusta—, pero también bacterias vivas (alimentos fermentados como chucrut, kombucha, kéfir…).
La alimentación no debe incluir demasiados alimentos dañinos, como los que contienen emulsionantes y edulcorantes.
La moderación de ciertos medicamentos (antibióticos, antiácidos, laxantes, ansiolíticos…), la supresión del alcohol y el tabaco, y la práctica de una actividad física regular también son medios poderosos de favorecer el buen equilibrio de la microbiota.
Cuando los microbios van mal, nuestro cuerpo paga el pato
Ya sabe que los microbios son responsables de multitud de enfermedades infecciosas: el rinovirus produce resfriados; el virus SARS-CoV-2, la COVID-19; la bacteria Salmonella, la gastroenteritis; el hongo Candida, la candidiasis… Por fortuna, los antimicrobianos (antibióticos, antivirales, antifúngicos…) actualmente permiten curar la mayoría de las infecciones causadas por los microorganismos.
Resistencia de los microorganismos a los antimicrobianos: ¡atención, peligro!
Problema: debido a una utilización excesiva de estos tratamientos, se observa desde hace unos años la proliferación de bacterias, virus y hongos que se han vuelto resistentes a estos. Por ejemplo, algunas bacterias patógenas ya no responden a ningún antibiótico; se habla de bacterias «multirresistentes» o «superbacterias». Por eso, algunas enfermedades que se podían curar (infecciones urinarias, infecciones de transmisión sexual u hospitalarias, diarreas, tuberculosis…) hoy pueden ser difíciles o incluso imposibles de tratar 9.
La resistencia a los antimicrobianos, reconocida por la OMS como un problema de salud pública, podría acabar con la vida de hasta 10 millones de personas al año de aquí a 2050 (tantas como el cáncer) 10. La OMS recomienda limitar el uso de los antimicrobianos, sobre todo de los antibióticos, en la ganadería, la salud humana o la agricultura, pero, sobre todo, insta a encontrar nuevos tratamientos más eficaces para luchar contra las infecciones.
La Semana Mundial de Concienciación sobre la RAM (WAAW) se celebra cada año del 18 al 24 de noviembre. En 2023, al igual que en 2022, el tema es «Prevenir juntos la resistencia a los antimicrobianos». La resistencia a los antimicrobianos es una amenaza no solo para los seres humanos, sino también para los animales, las plantas y el medio ambiente.
El objetivo de la campaña es, por tanto, concienciar sobre la resistencia a los antimicrobianos y promover las mejores prácticas, basadas en el concepto «Una sola salud», entre todas las partes interesadas (público en general, médicos, veterinarios, ganaderos y agricultores, responsables de la toma de decisiones, etc.) para reducir la aparición y propagación de infecciones resistentes.
Desequilibrios que abonan el terreno a las enfermedades de la civilización 3, 5, 8
Pero los microorganismos no solo son responsables de enfermedades infecciosas. ¿Sabía que también están implicados en la obesidad, la diabetes, la osteoporosis, el cáncer e incluso las enfermedades vasculares y neurodegenerativas (Parkinson, Alzheimer…)?
En efecto, los estudios demuestran que las personas que padecen estas enfermedades presentan un desequilibrio de la microbiota llamado « (sidenote: Disbiosis La disbiosis no es un fenómeno homogéneo ya que varía en función del estado de salud de cada individuo. Se define generalmente como una alteración de la composición y funcionamiento de la microbiota, provocada por un conjunto de factores ambientales y relacionados con el individuo, que alteran el ecosistema microbiano. Levy M, Kolodziejczyk AA, Thaiss CA, et al. Dysbiosis and the immune system. Nat Rev Immunol. 2017;17(4):219-232. ) ». La disbiosis se caracteriza por una pérdida de abundancia y diversidad de las poblaciones microbianas, sobre todo intestinales. Numerosos estudios demuestran que este desequilibrio puede tener un impacto negativo sobre el funcionamiento del organismo y favorecer la aparición o el empeoramiento de las enfermedades.
Los datos actuales no permiten saber de forma precisa si la disbiosis es una causa de la enfermedad o si la enfermedad es una causa de la disbiosis. No obstante, los estudios tienden a indicar que, favoreciendo una microbiota «sana» abundante y diversificada, o equilibrándola, sería posible preservar la salud.
¿Ha oído hablar de la «disbiosis»?
Modular la microbiota para prevenir enfermedades e incluso… ¡curarlas!
Existen varios medios de modular positivamente la microbiota intestinal en caso de disbiosis o enfermedad 3, 7 :
- La alimentación y el estilo de vida (véase anteriormente).
- Los prebióticos (inulina, galactooligosacáridos [GOS], fructooligosacáridos [FOS] y lactulosa): estos compuestos son capaces de alimentar específicamente a grupos de bacterias beneficiosas, como Bifidobacterium y Lactobacillus, y favorecer así su proliferación 11.
- Los probióticos (cepas específicas de bacterias o levaduras vivas con un efecto demostrado para la salud); por el momento, solo existen pruebas científicas de su eficacia en la diarrea infantil o la diarrea asociada a la toma de antibióticos, ciertas enfermedades inflamatorias del intestino o también la enterocolitis necrosante, pero su potencial terapéutico es objeto de numerosas investigaciones 11.
- Los (sidenote: Metabolitos Moléculas pequeñas producidas durante el metabolismo celular o bacteriano. Por ejemplo, los ácidos grasos de cadena corta son metabolitos producidos por la microbiota intestinal durante la fermentación de azúcares complejos no digeribles (fibras…). Silva YP, Bernardi A, Frozza RL. The Role of Short-Chain Fatty Acids From Gut Microbiota in Gut-Brain Communication. Front Endocrinol (Lausanne). 2020;11:25. Lamichhane S, Sen P, Dickens AM, et al An overview of metabolomics data analysis: current tools and future perspectives. Comprehensive analytical chemistry. 2018 ; 82: 387-413 ) bioactivos: estos se seleccionan por su capacidad de modular la fisiología de los microorganismos diana.
- La transferencia de microbiota fecal (TMF) consiste en transferir la microbiota intestinal de una persona sana al intestino de una persona enferma. Por ejemplo, esta técnica ha producido resultados contundentes (90% de curación) en las infecciones por Clostridium difficile 12, pero también podría ser útil para aliviar los síntomas del autismo 13.
El mundo microbiano, un reservorio infinito de pistas terapéuticas
Los microorganismos constituyen un campo de exploración valioso para los investigadores. Por ejemplo, para luchar mejor contra la resistencia bacteriana a los antibióticos y poder disponer de herramientas de control, los científicos necesitan comprender mejor cómo las bacterias intercambian sus genes, cómo adquieren resistencia a los antimicrobianos y por qué vías estas circulan entre el entorno, el ser humano y el animal 10.
Las técnicas de genómica de alta resolución y de metagenómica, ampliamente utilizadas en los estudios sobre la microbiota humana, constituyen, en este sentido, potentes herramientas de exploración de las dinámicas microbianas.
La microbiota en la encrucijada de las investigaciones
También se llevan a cabo cada vez más estudios para comprender mejor cómo interactúan los microorganismos de la microbiota con el ser humano, cómo contribuyen al buen funcionamiento de sus células, cuáles son los perfiles microbianos más favorables para la salud y qué modificaciones contribuyen a las enfermedades 3.
Objetivo: encontrar nuevas pistas terapéuticas y nuevas bacterias probióticas que permitan modular la microbiota y tratar con más eficacia ciertas enfermedades agudas y crónicas.
Algunas pistas prometedoras
- Ciertas sustancias producidas de forma natural por las bacterias, como las bacteriocinas, podrían utilizarse para elaborar nuevos tratamientos capaces de eliminar los microorganismos patógenos o frenar su desarrollo. Otras moléculas procedentes del metabolismo de las bacterias, como los (sidenote: Ácidos Grasos de Cadena Corta (AGCC) Los Ácidos Grasos de Cadena Corta (AGCC) son una fuente de energía (carburante) de las células de la persona que interactúan con el sistema inmunitario y están implicadas en la comunicación entre el intestino y el cerebro. Silva YP, Bernardi A, Frozza RL. The Role of Short-Chain Fatty Acids From Gut Microbiota in Gut-Brain Communication. Front Endocrinol (Lausanne). 2020;11:25. ) , también podrían emplearse por sus múltiples beneficios para la salud, sobre todo por sus efectos antiinflamatorios o antineoplásicos.
- La modulación genética de bacterias como Escherichia coli podría hacerlas capaces de producir diferentes tipos de moléculas interesantes: algunas destinadas a modular positivamente la microbiota en caso de disbiosis inducida por antibióticos, otras que actúan como vacuna para luchar contra Vibrio cholera (la bacteria responsable del cólera) y otras capaces de matar específicamente ciertos patógenos como Pseudomonas aeruginosa, una bacteria que causa estragos en las personas inmunodeprimidas.
- Por último, los bacteriófagos podrían utilizarse para actuar específicamente contra las bacterias resistentes a los antibióticos en caso de infección, lo cual constituiría una alternativa potencialmente poderosa a los antibióticos.
Como habrá comprendido, a pesar de su naturaleza invisible y su mala reputación, los microorganismos merecen toda nuestra estima y nuestra atención. ¡Porque está claro que los necesitamos para vivir!
A pesar de que las comunidades que forman, las interacciones que tienen con el entorno y el papel que desempeñan en nuestro organismo, todavía están llenos de misterio. ¡No pasa un día sin que un nuevo estudio demuestre la importancia de su presencia a nuestro lado y, por lo tanto, la de reforzar nuestra simbiosis con ellos!
La microbiota: ¡una red bien conectada en favor de la salud!
1. Site Web : Fondation Tara
2. Microbiology by numbers. Nat Rev Microbiol. 2011 Sep;9(9):628.
3. Aggarwal N, Kitano S, Puah GRY, et al. Microbiome and Human Health: Current Understanding, Engineering, and Enabling Technologies. Chem Rev. 2023 Jan 11;123(1):31-72.
4. Site Web Microbiology Society : What is Microbiology ?
5. GBD 2016 Diarrhoeal Disease Collaborators. Estimates of the global, regional, and national morbidity, mortality, and aetiologies of diarrhoea in 195 countries: a systematic analysis for the Global Burden of Disease Study 2016. Lancet Infect Dis. 2018 Nov;18(11):1211-1228.
6. Ropars J, Caron T, Lo YC, et al. “La domestication des champignons Penicillium du fromage” [The domestication of Penicillium cheese fungi]. Comptes rendus biologies vol. 343,2 155-176. 9 Oct. 2020.
7. Hou K, Wu ZX, Chen XY, et al. Microbiota in health and diseases. Signal Transduct Target Ther. 2022 Apr 23;7(1):135.
8. McFarland LV. Normal flora diversity and functions, Taylor & Francis Online 2000, Vol. 12 P.193-207.
9. Aslam B, Khurshid M, Arshad MI, et al. Antibiotic Resistance: One Health One World Outlook. Front Cell Infect Microbiol. 2021 Nov 25;11:771510.
10. Un nouveau rapport appelle à agir d’urgence pour éviter une crise due à la résistance aux antimicrobiens – OMS, 29 avril 2019.
11. Quigley EMM. Prebiotics and Probiotics in Digestive Health. Clin Gastroenterol Hepatol. 2019 Jan;17(2):333-344.
12. Stone L. Faecal microbiota transplantation for Clostridioides difficiles infection. Nature Reviews Urology, June 2019.
13. Kang DW, Adams JB, Coleman DM, et al. Long-term benefit of Microbiota Transfer Therapy on autism symptoms and gut microbiota. Sci Rep. 2019 Apr 9;9(1):5821.
14. Quigley EMM, Gajula P. Recent advances in modulating the microbiome. F1000Res. 2020 Jan 27;9:F1000 Faculty Rev-46.
BMI-24.12
Véase también